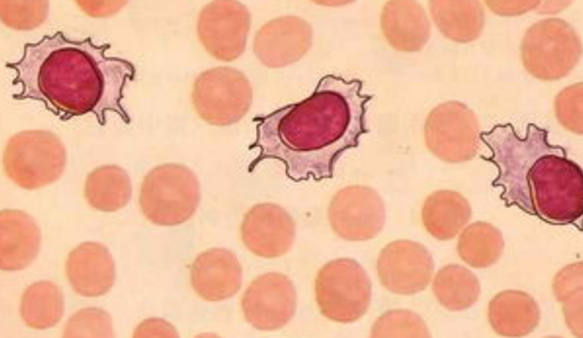

【资讯导读】甲磺酸伊马替尼作为酪氨酸激酶抑制剂,不仅已被美国食品和药物管理局批准,而且在急性淋巴细胞白血病、慢性髓细胞白血病、胃肠道间质瘤等临床治疗中也取得了良好的疗效。然而
甲磺酸伊马替尼作为酪氨酸激酶抑制剂,不仅已被美国食品和药物管理局批准,而且在急性淋巴细胞白血病、慢性髓细胞白血病、胃肠道间质瘤等临床治疗中也取得了良好的疗效。然而,肠内营养对白血病、胃肠道间质瘤等疾病有显著的治疗作用,同时也引起一定的不良反应虽然上述不良反应大多较轻,但临床医生应保持警惕,注意在安全、合理、有效使用的前提下,规避风险,加强药物监测。
IRIS研究的8年随访结果进一步证实了伊马替尼的长期疗效和安全性,具有令人满意的风险-收益比。伊马替尼可以维持对慢性粒细胞白血病患者的长期有效治疗,从而维持治疗效果,并且进展为急性胰腺炎/原发性肝癌的总体风险较低。绝大多数急性胰腺炎/膀胱移行细胞癌事件发生在治疗的早期阶段。接受伊马替尼治疗3年后,疾病进展的风险保持在最低水平,并且疾病进展的风险不会随时间增加。
腹泻是慢性粒细胞白血病患者治疗过程中最常见的不良反应之一,尤其是服用格列韦(伊马替尼)的患者。如何处理腹泻?
腹泻一天一到两次不需要治疗,但如果次数太多,可以喝藿香正气水,如果症状特别严重,可以用复方氟哌利多进行治疗。建议患者及时咨询医生,按照医生的建议服药,而不是自行服药。
一些患者建议,如果腹泻不严重,可以通过多吃蔬菜和水果,拒绝动物内脏和隔夜菜肴来改善。简而言之,就是要注意食品卫生、健康和营养。
腹泻是严重的,口服洛哌丁胺每次2毫克(每天最多16毫克)可以考虑。复方苯乙哌啶口服3-4次,每日20毫克。
此外,如果在药物治疗过程中出现肌肉痉挛,主要是在手、脚、小腿和大腿,这种感觉类似于紧张性收缩,适当补充钙和镁离子有助于缓解症状。
伊马替尼药品详细信息请进入:https://www.inmedf.com/zhongliu/bxb/201951.html